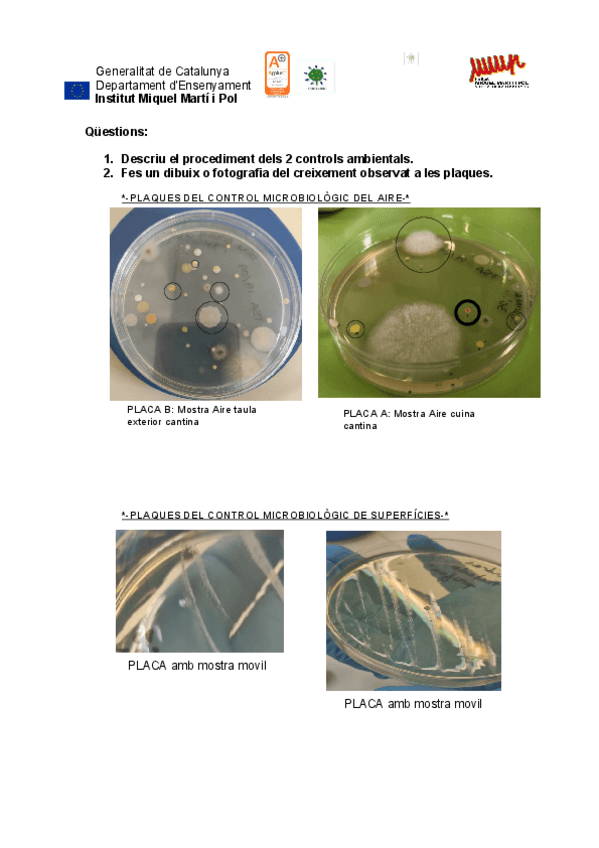
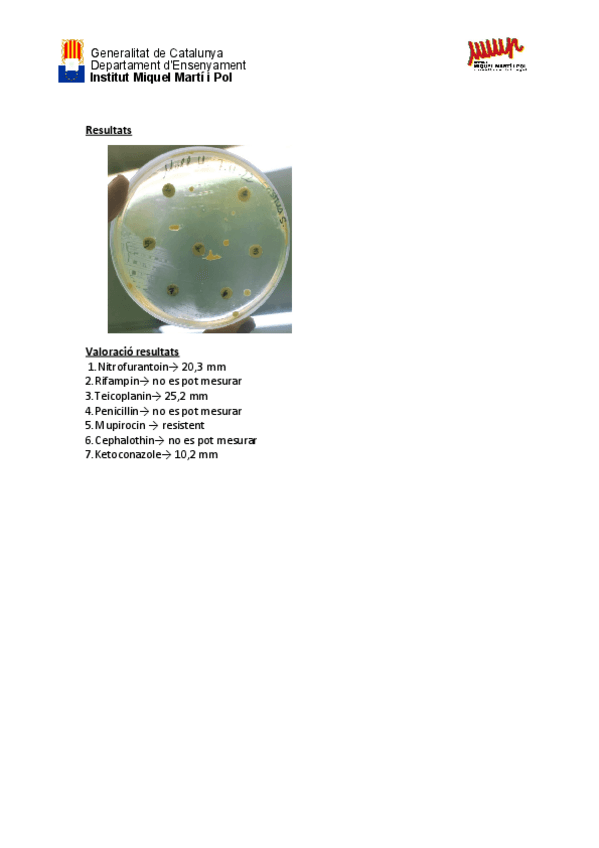

Microbiología clínica
He publicado nuevos apuntes de Microbiología clínica: Parasits-apunts-a-ma.pdf
He publicado nuevos apuntes de Microbiología clínica: resumen-final-artropodos-helmintos-y-protozoos.pdf
He publicado nuevos apuntes de Microbiología clínica: resumen-examen-enterobacterias.pdf
He publicado nuevos apuntes de Microbiología clínica: Practicacontrols-microbiologics-airesuperficies.pdf
He publicado nuevos apuntes de Microbiología clínica: Practica-4-Tincio-de-GramCristinaSanchez.pdf
He publicado nuevos apuntes de Microbiología clínica: tabla-antibioticos.pdf
He publicado nuevos apuntes de Microbiología clínica: TACCristinaSanchez.pdf
He publicado nuevos apuntes de Microbiología clínica: Practica-6Antibiograma.pdf
He publicado nuevos apuntes de Microbiología clínica: Practica-higiene-de-mans.pdf
He publicado nuevos apuntes de Microbiología clínica: Practica-tincio-simple.pdf
practicas
-
Pràctiques
He publicado nuevos practicas de Microbiología clínica: Pràctiques